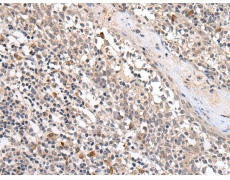
一抗

中文名稱: 兔抗PROK1多克隆抗體
英文名稱: Anti-PROK1 rabbit polyclonal antibody
別 名: PK1; PRK1; EGVEGF
相關(guān)類別: 一抗
儲(chǔ) 存: 冷凍(-20℃)
宿 主: Rabbit
抗 原: PROK1
反應(yīng)種屬: Human, Mouse, Rat
標(biāo) 記 物: Unconjugate
克隆類型: rabbit polyclonal
技術(shù)規(guī)格
|
Background: |
The protein encoded by this gene induces proliferation, migration, and fenestration (the formation of membrane discontinuities) in capillary endothelial cells derived from endocrine glands. It has little or no effect on a variety of other endothelial and non-endothelial cell types. Its expression is restricted to the steroidogenic glands (ovary, testis, adrenal, and placenta), is induced by hypoxia, and often complementary to the expression of vascular endothelial growth factor (VEGF), suggesting that these molecules function in a coordinated manner. |
|
Applications: |
ELISA, IHC |
|
Name of antibody: |
PROK1 |
|
Immunogen: |
Synthetic peptide of human PROK1 |
|
Full name: |
prokineticin 1 |
|
Synonyms: |
PK1; PRK1; EGVEGF |
|
SwissProt: |
P58294 |
|
ELISA Recommended dilution: |
5000-10000 |
|
IHC positive control: |
Human tonsil |
|
IHC Recommend dilution: |
25-100 |

 購(gòu)物車
購(gòu)物車 幫助
幫助
 021-54845833/15800441009
021-54845833/15800441009